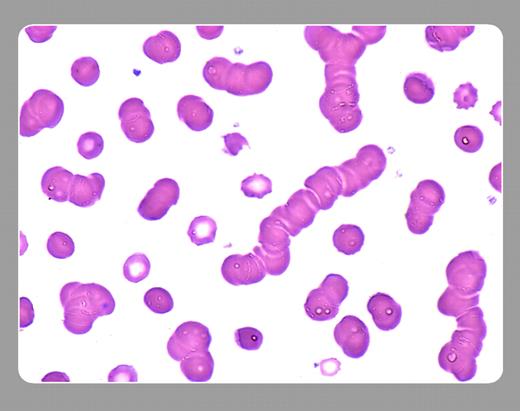
Peter Maslak, Memorial Sloan-Kettering Cancer Center

Topics:
rouleaux
Red cells may align into a configuration that resembles a “stack of coins” based on the presence of an increased amount of plasma proteins, typically gamma globulins, on their surface. This peripheral smear is from a patient with multiple myeloma.FIG1
Many Blood Work images are provided by the ASH IMAGE BANK, a reference and teaching tool that is continually updated with new atlas images and images of case studies. For more information or to contribute to the Image Bank, visit www.ashimagebank.org.
Copyright © 2005 by The American Society of Hematology
2005
Peter Maslak, Memorial Sloan-Kettering Cancer Center